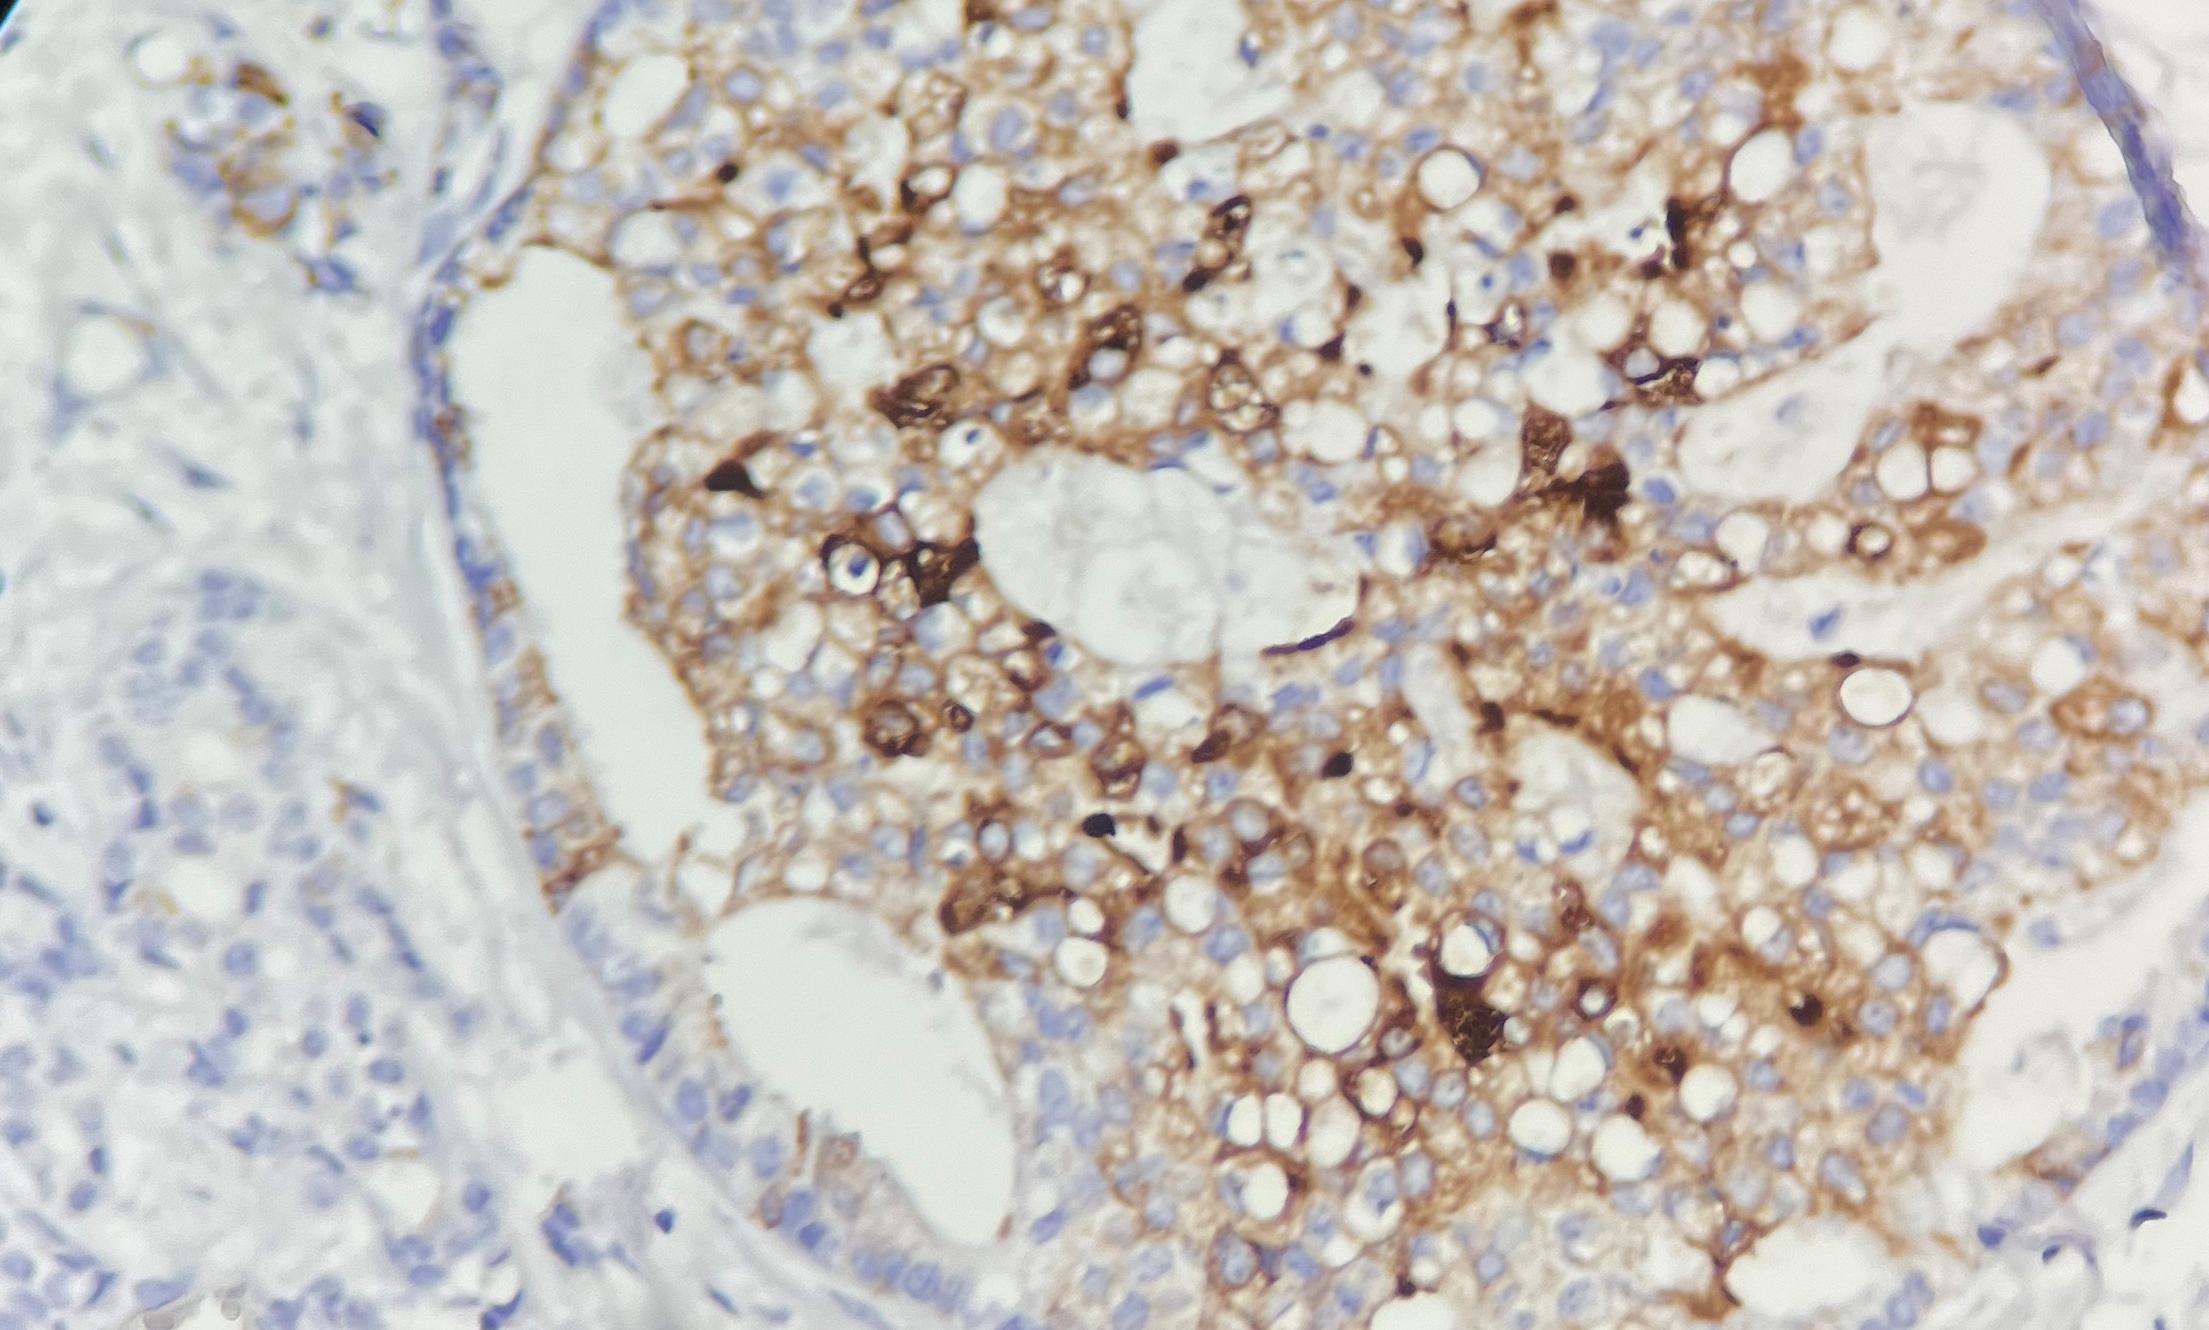

Mammaglobin抗体试剂
Mammaglobin抗体试剂
乳腺珠蛋白
产品描述
Mammaglobin抗体 是一种特异性识别乳腺特异性10kDa糖蛋白的免疫检测工具,该蛋白在正常组织中仅表达于成人乳腺和汗腺(但汗腺肿瘤中缺失)。作为乳腺癌的高特异性标志物,其价值体现在:①免疫组化检测可识别高达85%的乳腺癌病例;②通过RT-PCR检测外周血循环肿瘤细胞中的mammaglobin mRNA,其表达水平与淋巴结转移等预后因素显著相关。该抗体在乳腺癌诊断、转移监测及预后评估中具有重要临床意义,尤其有助于鉴别乳腺来源的转移性腺癌。
参考文献
产品信息
备案名称:
乳腺珠蛋白(Mammaglobin)抗体试剂
备案证号:
粤深械备 20221645
产品型号:
DMRD0221
适用:
阳性部位:
细胞质
预 处 理:
产品规格
| 类型 | 即用型 | 浓缩型 | ||||
| 规格 | 1ml | 3ml | 6ml | 10ml | 0.1ml | 0.2ml |


